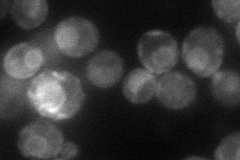
YIR033W

View description
ER membrane protein involved in regulation of OLE1 transcription, acts with homolog Spt23p; inactive ER form dimerizes and one subunit is then activated by ubiquitin/proteasome-dependent processing followed by nuclear targeting
Localization:
Intensity:
Fold change:
Significance:
-
C’ GFP library in SD

below threshold17.32 -
N' NOP1pr-GFP in SD
ER51.753 -
N' TEF2pr-mCherry in SD

ER45.8503 -
N' NATIVEpr-GFP in SD

ambiguous,ER25.0088 -
N' TEF2pr-VC and Cyto-VN in SD

ER39.8915 -
C’ GFP library in SD+DTT

cytosol21.971.26No -
C’ GFP library in SD+H2O2

cytosol20.281.17No -
C’ GFP library in Starvation Media

cytosol16.970.97No -
C’ GFP library on the background of Pup2-DaMP

below threshold -
C’ GFP library on the background of CCT mutant

below threshold15.42210.889942No
